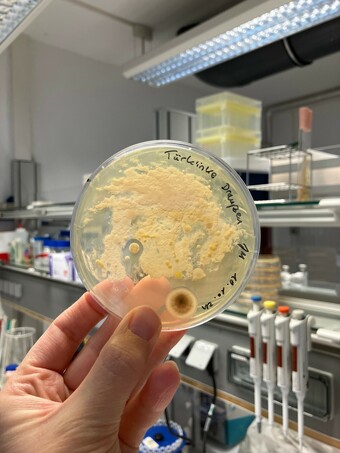

Navigation
Detail
Abklatschplatte Türklinke öffentliches Gebäude
Urheber:
Stefanie Müller-Kröckel
Bildnummer:
P17985
Auflösung:
1512x2016
Format:
PNG
Quelle:
https://www.schulportal-thueringen.de/pixiothek/detail?tspi=P17985
Kurzbeschreibung:
Das Bild zeigt einen Abklatsch-Test einer Türklinke in einem öffentlichen Gebäude mittels Abklatschplatte bzw. Fangplatte. Entstanden ist das Bild im Zuge der Ausbildung zum Biologielaboranten/ zur Biologielaborantin an der Uni Jena. Es gelten die Nutzungsbedingungen der Mediothek und Pixiothek.
Verwandte Bilder (Auswahl)

Bakterienkultur mit Antibiotika, Ingw...
(1200x1600)
Verwandte Medien (Auswahl)

FG099: Biodiversität von M...
(öffentlich) Die DSMZ in B...
Online-Medium
(2023)





